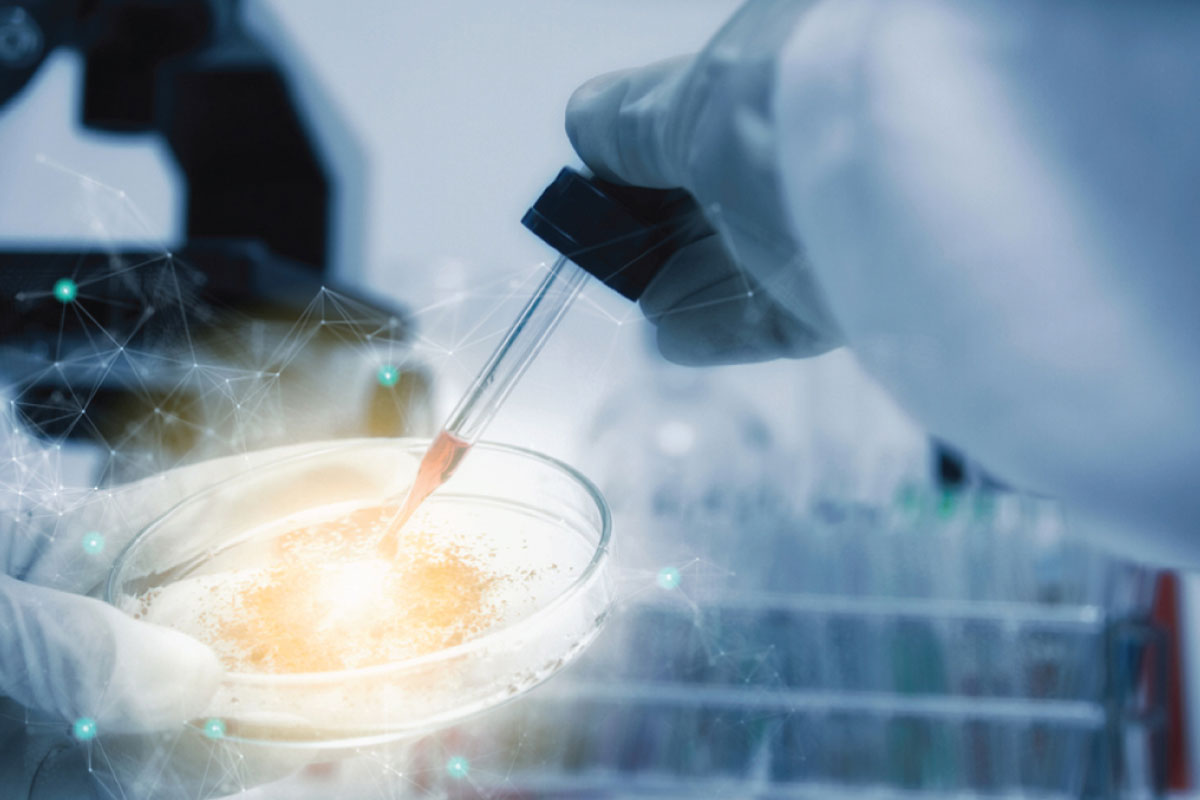

ABOUT US
Frischemie Speciality Performance Materials Pvt. Ltd.
Frischemie Speciality Performance Materials Pvt. Ltd., is a state-of-art speciality chemicals manufacturing company offering customized and cost-competitive solutions through our semi-speciality & speciality products. We are presently aligned to cater to the Textile & Cleantech industry segments.
WE BELIEVE
In setting benchmarks in providing solutions through.
- Continuous Innovation
- Sustainability & Enhanced Productivity
- Quality Management
- Optimum Utilisation of Resources
- Industry Compliant Procedures
- Reducing Carbon Footprints